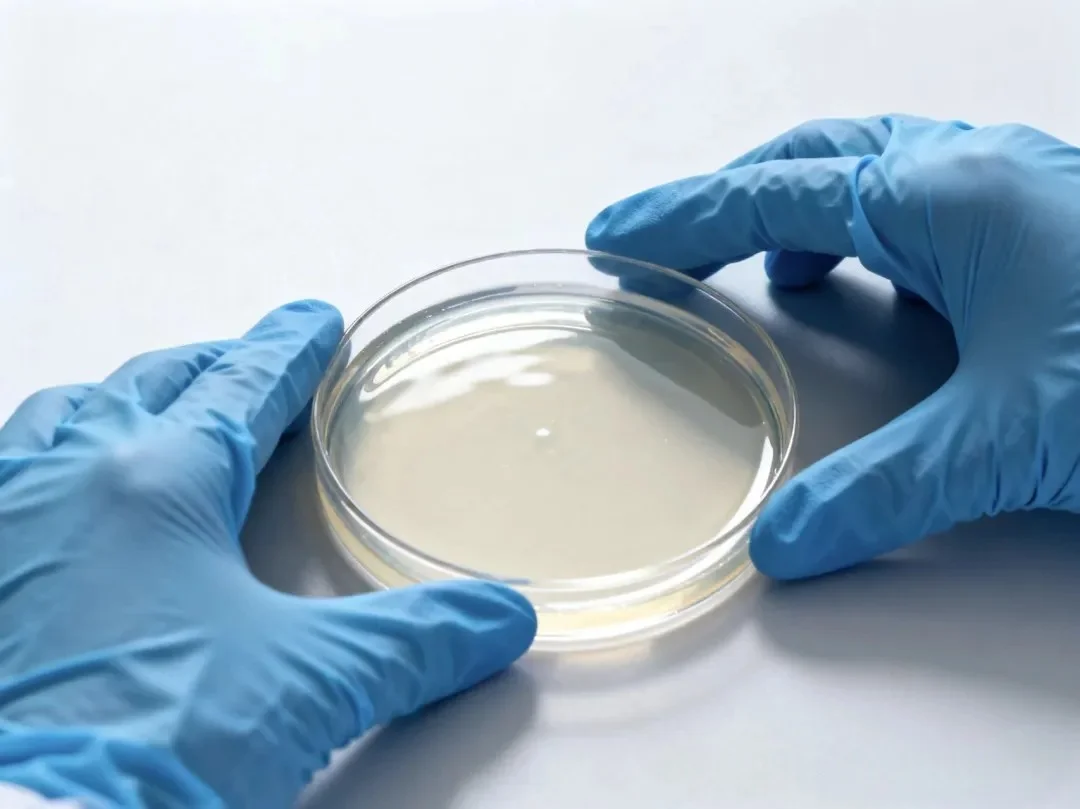
倒平板 倒平板
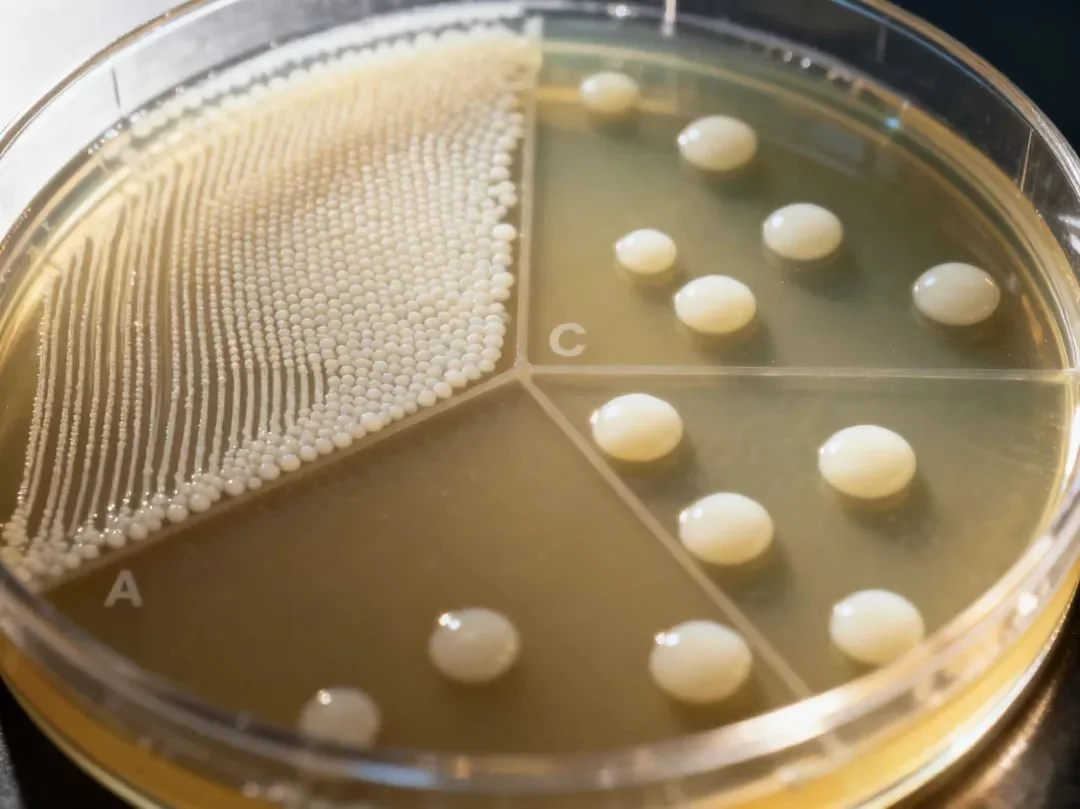
平板划线 平板划线

微生物实验基本功:倒平板、划线、涂布标准操作流程(SOP)详解。
发布时间:2025-09-17 浏览次数:761
每一位与微生物打交道的实验者,都像是一位在微观世界里耕耘的匠人。我们所用的工具、所持的手法,决定了我们能否窥见那个世界的真实与纯粹。倒平板、划平板、涂布——这三项看似基础的操作,实则是我们与微生物对话的起点,是一切精彩发现的基石。今天,就让我们以资深者的视角,重新审视这三项核心技艺的精髓。
第一章:无菌之道
在我们开始之前,必须将“无菌操作”这四个字刻入骨髓。它不仅仅是一套程序,更是一种实验信仰。任何后续操作的精准与优雅,都建立在绝对无菌的前提之上。
● 环境是延伸的“手套”:超净工作台或生物安全柜(处理病原体时必须使用)是我们双手的延伸。每次实验前足够的紫外灭菌时间、工作期间的酒精消毒,是对自己也是对样本的负责。
● 火焰是无菌的边界:酒精灯火焰旁那方寸之地,是我们构建的无菌核心区。试管口、瓶口、培养皿盖的开启与关闭,都必须在此区域内进行,并且瞬间掠过火焰,利用热空气形成屏障。记住,动作要敏捷而从容,慌乱的快速反而会搅动气流,增加污染风险。
● 工具是双手的延续:接种环、涂布棒,如同外科医生的手术刀。使用前彻底灼烧至红热,使用后同样彻底灼烧,这是对下一个操作、下一个样本最基本的尊重。交叉污染是实验失败和错误结果的罪魁祸首。

第二章:倒板之匠心
倒平板,是为微生物准备一个“家”。这个家是否舒适、稳固,直接关系到后续“居民”的生长状态。
1. 温度的奥秘:将熔化的琼脂培养基冷却至45-50℃(手感温热但不烫手玻璃瓶)是成败的关键。过热,会产生大量冷凝水,冲刷尚未生长的菌落,甚至烫死待接种的菌;过冷,琼脂凝块则无法形成光滑均匀的平面。这份对温度的掌控,源于经验,更源于耐心。
2. 细节决定品质:
■ 倾注:沿培养皿壁的一侧缓缓注入,避免气泡产生。如若产生,可在火焰上短暂灼烤除去。
■ 旋转:盖上皿盖后,轻轻水平旋转,让培养基自然流平,切忌剧烈晃动,否则培养基易沾在皿盖或壁上部,成为污染源。
■ 凝固:静置于绝对水平的台面上,耐心等待它完全凝固。倾斜的平板会导致培养基厚度不一,影响实验结果的均一性。
3. 储存:凝固后的平板应倒置,放入密封袋中,于4℃保存。倒置可防止冷凝水滴落砸坏菌落;密封可防止培养基失水干裂。一个好的平板,是成功的一半。
第三章:划线之韵
划线分离,是实验中最富美感的一幕。它要求我们像画家一样,手腕灵动,心中有图。
1. 工具的冷却:灼烧后的接种环,必须冷却!这是无数新手倒下的第一个坑。将其轻触无菌琼脂边缘,听一声轻微的“呲”声,或是在空气中静置数秒,待热量散尽再取菌。否则,你取到的只是一堆被烫死的菌体。
2. 分区的智慧:
标准的四区划线法,目的是实现菌落的梯度稀释。
■ A区(一区):蘸取菌样后,在此区域密集来回划线,约占1/4面积。这里是菌落的“原爆点”。
■ B区(二区):灼烧冷却接种环,从A区末端引出1-2条线,然后在新的空白区域(B区)进行稀疏一些的划线,线与线间留有间隙。关键:确保每次划线都从前一区的末端开始,以实现有效稀释。
■ C/D区:重复上述灭菌、引线、划线的过程。理想情况下,在第三或第四区,你会收获梦寐以求的孤立的单菌落——它们通常圆润、光滑、大小均一,是一个纯培养群体的起源。
3. 手感:接种环与琼脂表面应呈30-40°角,力度轻柔,如春风拂面,只需在表面留下划痕,而非沟壑。划破琼脂不仅影响菌落形态,还可能将深处的厌氧菌带出,造成干扰。
第四章:涂布之准
当研究进入定量阶段,涂布平板便是我们的不二法门。它要求的是极致的均匀与精准。
1. 平板的状态:用于涂布的平板,表面必须干燥。若有冷凝水,会导致菌液蔓延,菌落连成一片,无法计数。可提前将平板倒置于37℃培养箱中烘干30分钟。
2. 涂布棒的灭菌:酒精浸泡后灼烧是最常用且高效的方法。注意待棒上酒精燃尽后,稍冷却几秒,或让其接触平板边缘无培养基处降温,再接触中央的菌液。热棒会瞬间杀死大量细菌,导致计数严重偏低。
3. 涂布的手法:
■ 将定量的菌液(通常0.1mL)滴加在平板中央。
■ 先静置片刻,让菌液自行渗入琼脂,减少流动。
■ 用冷却的涂布棒,轻柔而快速地从中心向外周旋转涂开,或呈放射状、同心圆状涂布。
■ 确保菌液覆盖整个表面,且被完全吸收。整个过程应在火焰旁快速完成。
4. 应用场景:此法至关重要,广泛应用于食品药品以及临床微生物实验室等多领域微生物检测,此操作直接指影响微生物检测结果,容不得半点马虎。
➤ 温馨提示
各位同仁,倒平板、划平板、涂布,这些我们日复一日重复的操作,早已超越了其技术本身。它们是我们实验哲学的体现:对规则的敬畏、对细节的执着、对结果的诚实。
每一次成功的分离,每一次精准的计数,背后都是这份匠心的支撑。在这个肉眼不可见的王国里,我们凭借这些最基础也最核心的技艺,成为敏锐的观察者和谨慎的探索者。愿你我都能在这方寸之间的平板之上,练就一双稳定的手和一颗宁静的心,游刃有余,洞见非凡。
FAQ问答模块:
Q1:倒平板的最佳温度是多少?
45–50℃,避免冷凝水和热杀菌体。
Q2:为什么划线要控制角度和力度?
接种环与琼脂保持30–40°角,力度轻柔,避免划破培养基。
Q3:涂布平板前为什么要烘干?
防止冷凝水影响菌液扩散,保证菌落均匀分布。
本文由环凯转载自“橙小白的实验屋”公众号,版权归原作者(橙小白)所有,仅供学习参考,如有侵权请联系删除!
